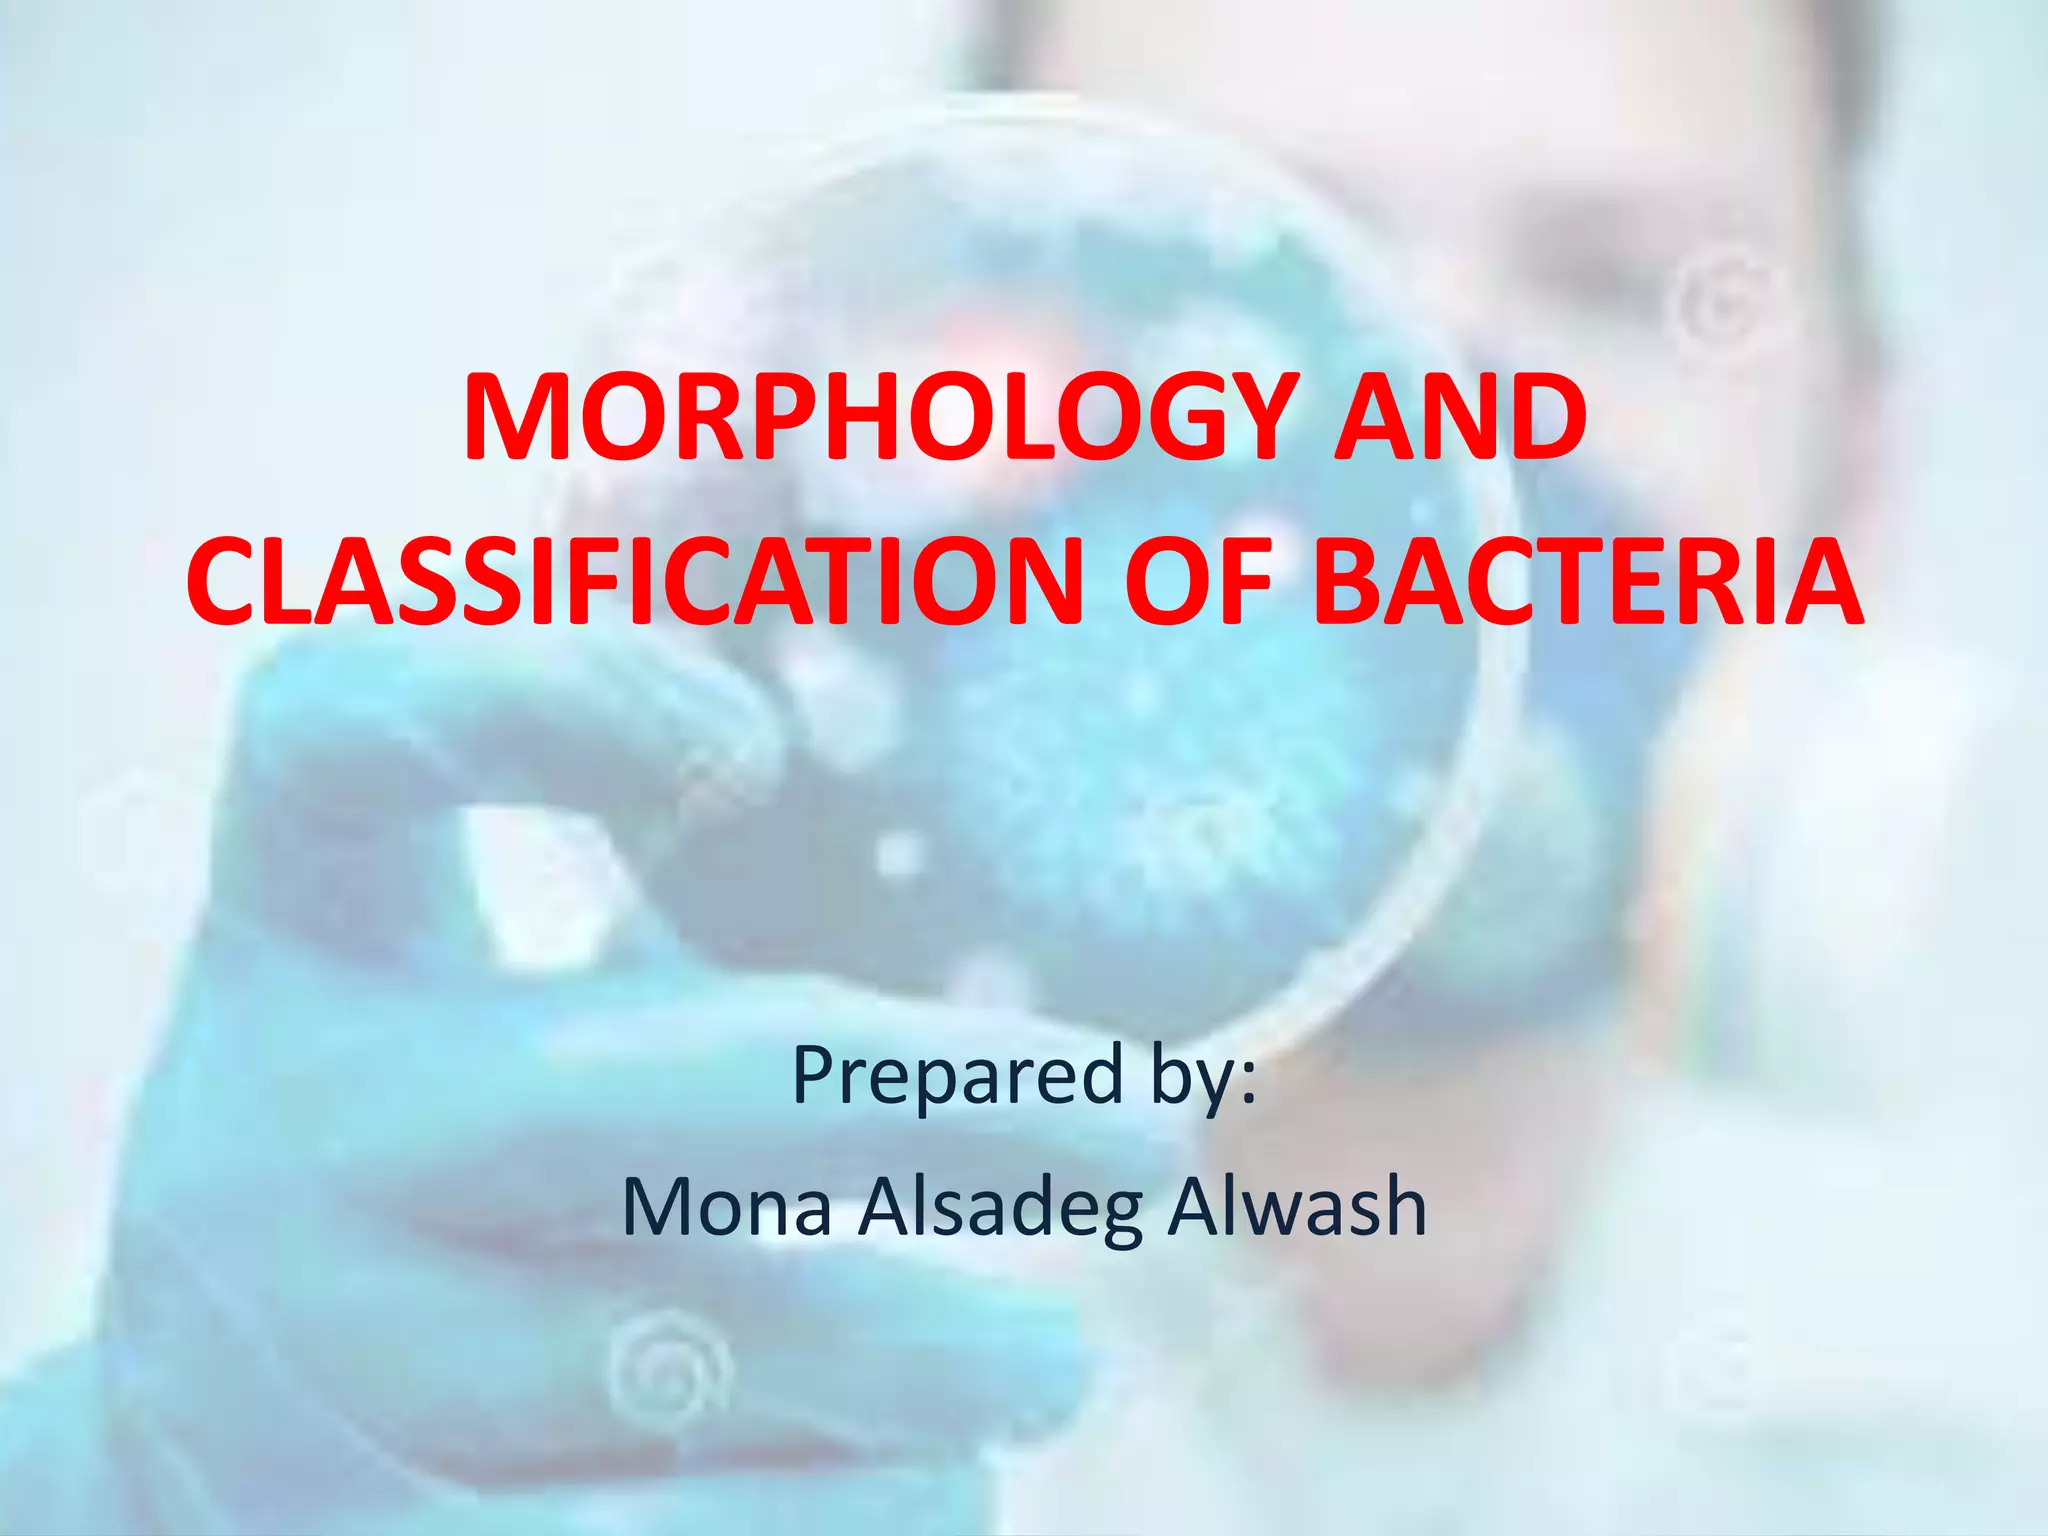
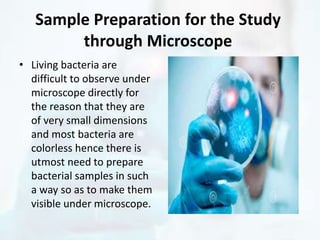
Sample Preparation for the Study
through Microscope
• Living bacteria are
difficult to observe under
microscope directly for
the reason that they are
of very small dimensions
and most bacteria are
colorless hence there is
utmost need to prepare
bacterial samples in such
a way so as to make them
visible under microscope.

The document explores the morphology and classification of bacteria, detailing the differences between prokaryotic and eukaryotic cells, with a focus on their structures, reproduction, and biological functions. It also describes various types of bacteria based on shape and arrangement, microscopy techniques for studying bacteria, and staining methods to enhance visibility under a microscope. Overall, it provides a comprehensive overview of bacteria's biological characteristics and their role in the environment.